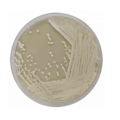
E-shop hlavní obrázek

Simmons citrát agar je selektivní půda určená na diferenciaci enterobakterií na základě schopnosti využívat citrát.

Kultivační půda využívaná pro rozlišeni enterobakterií na základě jejich schopnosti využívat citrát.
Produkt je dodáván v dehydratované formě a je určen pro přípravu hotových kultivačních médií.

Antibiotické disky jsou papírové disky se speciálními vlastnostmi, které jsou impregnovány antibiotiky a používají se pro testování dle Kirby-Bauer metody stanovení antibiotické citlivosti.
Médium s vysokou koncentrací maltózy určené pro kultivaci hub a kvasinek.
Produkt je dodáván v dehydratované formě a je určen pro přípravu hotových kultivačních médií.

Slanetz Bartley agar je kultivační půda, která se používá pro detekci a enumeraci intestinálních enterokoků pomocí membránové filtrace nebo miskové techniky.

Slanetz Bartley agar je kultivační půda, která se používá pro detekci a enumeraci intestinálních enterokoků pomocí membránové filtrace nebo miskové techniky.

ELISA souprava na kvantitativní stanovení SLPI v lidské plazmě, séru, sputu, moči a dalších tělních tekutinách.

AESKULISA Sm je enzymoimunoanalytická souprava pro kvantitativní a kvalitativní detekci protilátek proti Sm v lidském séru.

Diagnostická reagencie pro in vitro kvantitativní stanovení sodíku v séru nebo plazmě fotometricky.

Antibiotické disky jsou papírové disky se speciálními vlastnostmi, které jsou impregnovány antibiotiky a používají se pro testování dle Kirby-Bauer metody stanovení antibiotické citlivosti.

Analyzuje somatické varianty zahrnující SNV a InDels v deseti klíčových genech spojených s rakovinou, a také detekci genových fúzí způsobených strukturálními variacemi ve třech genech řídících rakovinu.

Diatabs™ identifikační tablety určené ke kvalitativní detekci mikrobiálních charakteristik při identifikaci mikroorganismů.

Izolační kit na bázi kolonek pro izolaci malých RNA molekul.

Kontrolní sérum Specitrol High je určeno pro použití jako kontrolní sérum pro sledování přesnosti testů pro stanovení konkrétních proteinů.

Antibiotické disky jsou papírové disky se speciálními vlastnostmi, které jsou impregnovány antibiotiky a používají se pro testování dle Kirby-Bauer metody stanovení antibiotické citlivosti.

AESKULISA Sphingomyelin-GM je enzymoimuno-analytická souprava pro kvantitativní a kvalitativní detekci IgG a/nebo IgM protilátek proti sphingomyelinu v lidském séru.

Antibiotické disky jsou papírové disky se speciálními vlastnostmi, které jsou impregnovány antibiotiky a používají se pro testování dle Kirby-Bauer metody stanovení antibiotické citlivosti.
